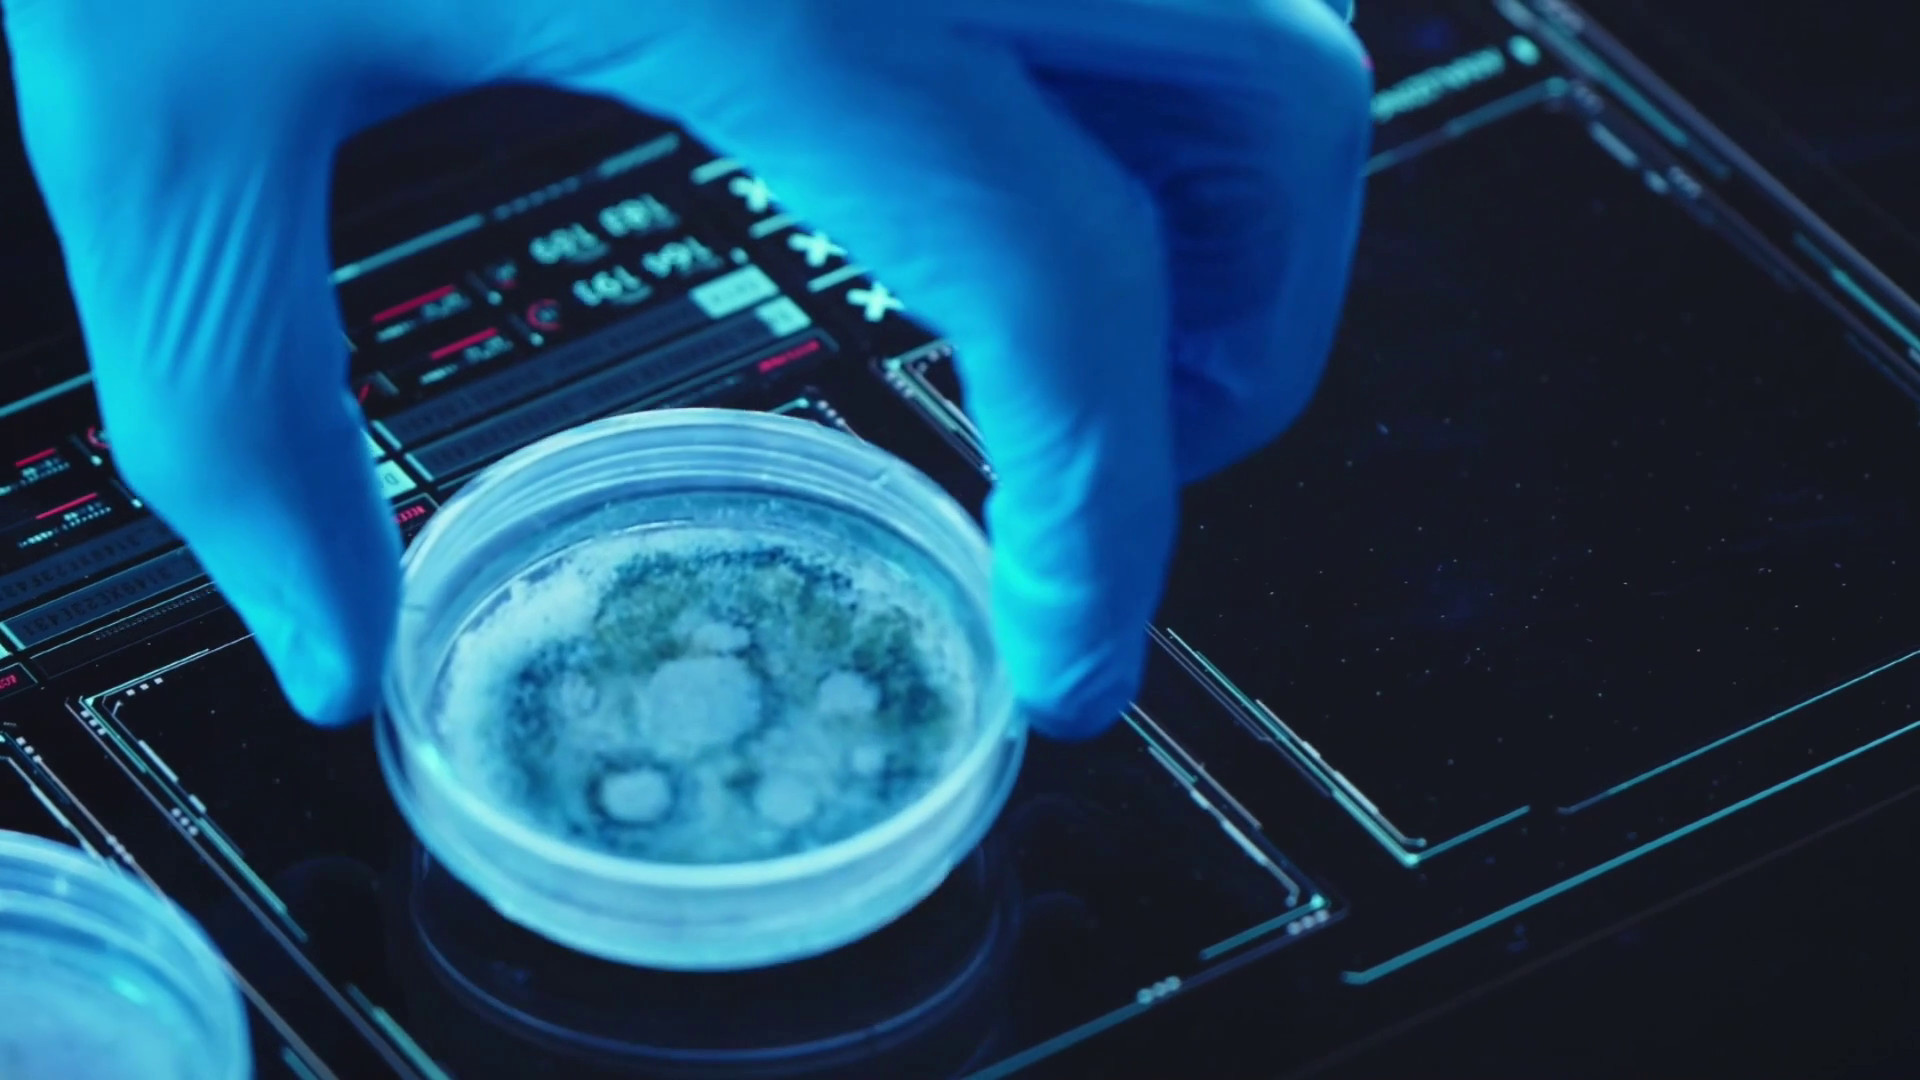

ROMA (ITALPRESS) – Un nuovo approccio diagnostico tridimensionale per osservare, in maniera quantitativa e senza marcatori fluorescenti, i “lisosomi”, all’interno di cellule vive. A svilupparlo un team congiunto dell’Istituto di scienze applicate e sistemi intelligenti del Consiglio nazionale delle ricerche di Pozzuoli e dell’Istituto Telethon di Genetica e Medicina. A spiegare il funzionamento della tecnologia Pietro Ferraro, Dirigente di Ricerca e Principal Investigator dell’Istituto di scienze applicate e sistemi intelligenti del CNR di Napoli.
sat/azn
sat/azn